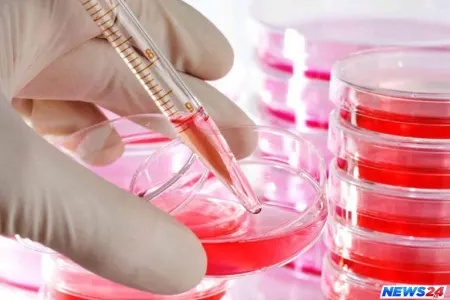
Bu il Azərbaycanda talassemiyalı 55 cütlük aşkarlanıb

29 dek 11:10, 2018
29 dek 11:10, 2018
Son xəbərlər
 29 dek 11:10, 2018
29 dek 11:10, 2018
 29 dek 10:55, 2018
29 dek 10:55, 2018
Arvadı atıb gedən kişi özünü asdı - Azərbaycanda
 29 dek 10:41, 2018
29 dek 10:41, 2018
Bakı-Gəncə sürət qatarı ilk reysə çıxdı - FOTO
 28 dek 19:00, 2018
28 dek 19:00, 2018
Prezident sərəncam imzaladı
 28 dek 18:45, 2018
28 dek 18:45, 2018
Ana və uşaq ölümlərinin sayı açıqlandı
 28 dek 18:31, 2018
28 dek 18:31, 2018
İTV loqosunu dəyişir
 28 dek 18:23, 2018
28 dek 18:23, 2018
Eldar Əzizov daha bir keçmiş kadrına vəzifə verdi
 28 dek 18:06, 2018
28 dek 18:06, 2018
Sibel Can konsertinin biletləri satışda
 28 dek 18:00, 2018
28 dek 18:00, 2018
Prezident icra başçısını təltif edib
 28 dek 17:52, 2018
28 dek 17:52, 2018
Bu il Azərbaycanda 12 nəfərə sümük iliyi köçürülüb
 28 dek 17:37, 2018
28 dek 17:37, 2018
2018-ci ildə ölümdən dönən yerli məşhurlar
 28 dek 17:25, 2018
28 dek 17:25, 2018
Azərbaycanda şok: “Ağzı bağlı torbanın içində zibillikdə uşaq meyiti tapıldı…” - Video
28 dek 17:17, 2018
28 dek 17:17, 2018
Bu il Azərbaycanda talassemiyalı 55 cütlük aşkarlanıb
 28 dek 17:02, 2018
28 dek 17:02, 2018
Bakıda kriminal hesablaşma: avtomatdan atəş açan Zaur İsmayılovdur
 28 dek 16:49, 2018
28 dek 16:49, 2018

